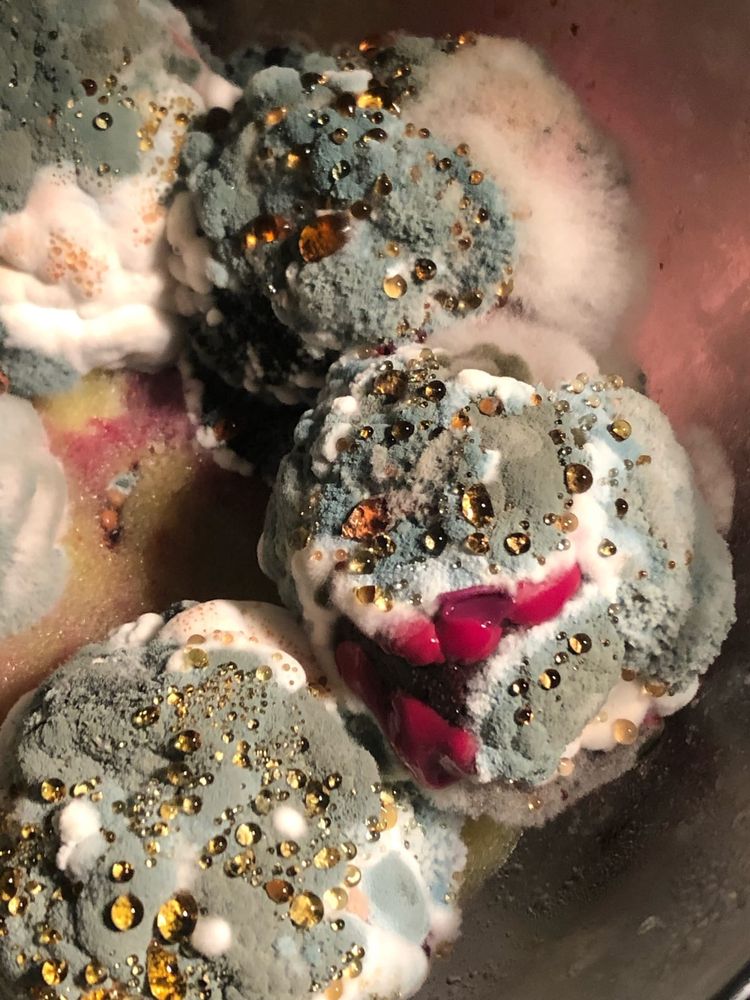
04-16-48-1618494516990883242

Все мы знаем об опасности плесени и о том, что, если она появляется на продуктах, мебели или стенах — это совсем нехороший признак. Вам едва ли захочется не только есть, но даже прикасаться к еде, покрытой плесенью, но иногда она принимает такие завораживающие и интересные формы, что не сфотографировать её было бы большой ошибкой.
Эта плесень выглядит как произведение искусства

"Овощной бульон, который пролежал в холодильнике несколько дней и покрылся вот такой причудливой плесенью"

Заплесневелые оливки выглядят весьма эстетично

"Мне кажется, если бы эта заплесневевшая картошка пролежала ещё пару дней, то вероятно, стала бы доминирующей расой на Земле"

А это плесневелый яблочный сок во всей своей красе

Пушистый лук

"Я подумала, что вам понравится мой заплесневевший томатный соус"

"Вот такая забавная плесень в форме кругов образовалась на моём забытом кофе"

"Не забывайте время от времени проверять, что лежит у задней стенки вашего холодильника..."

Красивая плесень, образовавшаяся на куске мягкого сыра

Эти апельсины заплесневели и стали выглядеть как звёзды

"Забыл на неделю спагетти с грибами в микроволновке. Теперь это шар плесени"

А так выглядит заплесневевший зелёный чай

Кто посеял траву на спагетти?

Солёные помидоры с плесенью выглядят так, словно усеяны бусинами

Этот лимон с плесенью похож на произведение авангардного искусства

Сливочный сыр (всё ещё с неистекшим сроком годности)

Что думаете об этой томатной причёске?

Красавица-свекла
Не забудьте оценить 20 забавных и познавательных фотографий, в которых позитива и интересностей хватит на весь день.
